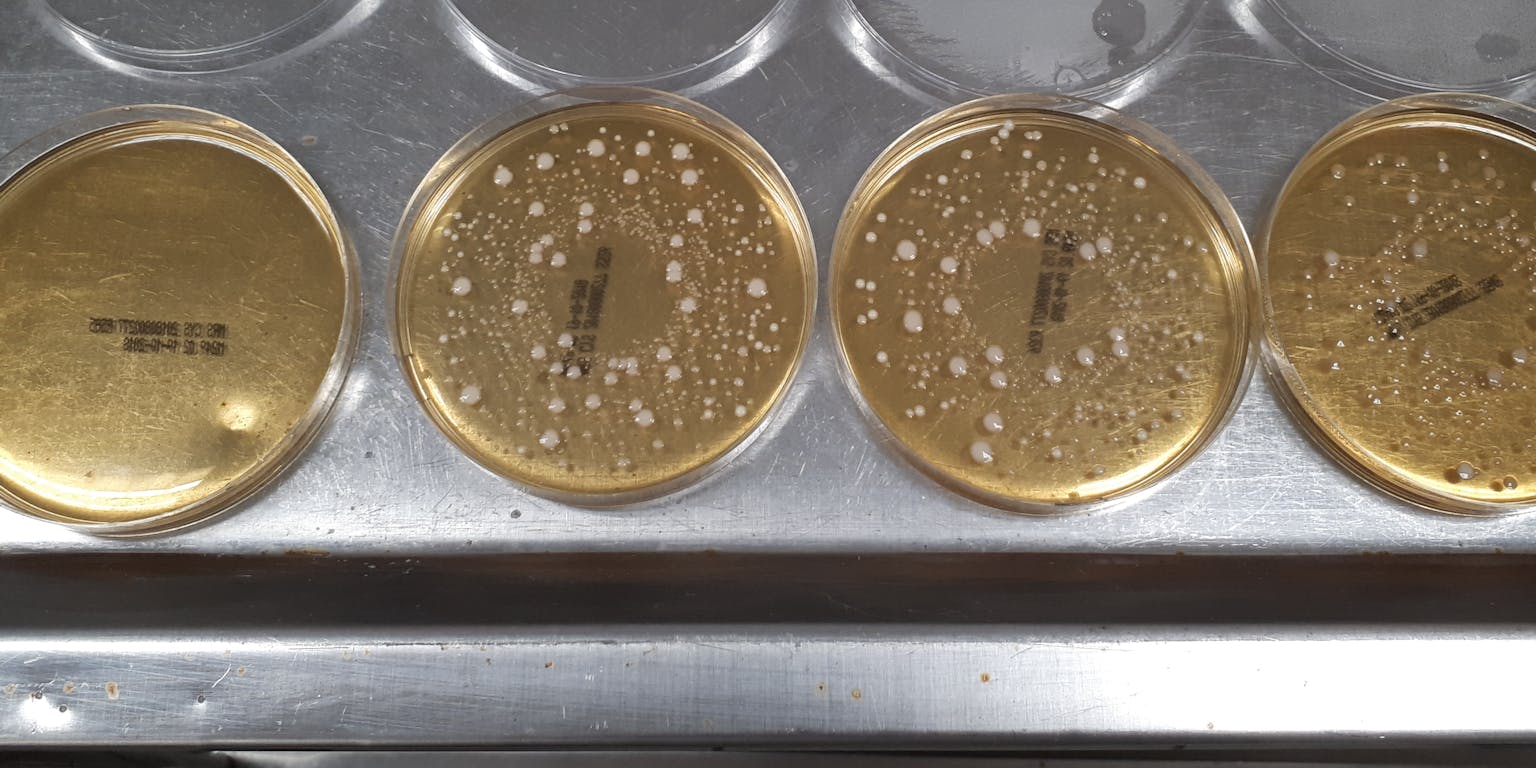

Gezonde bacteriën (probiotica) staan de afgelopen jaren volop in de belangstelling. Ze lijken een belangrijke rol te spelen bij darmaandoeningen, allergieën en zelfs hersenziekten. Bij Winclove Probiotics wordt veel onderzoek gedaan naar probiotica. NEMO Kennislink ging op bezoek.
Tussen de woonwinkels op een industrieterrein in Amsterdam-Noord staat een kantoor. Het is het onderkomen van probiotica-bedrijf Winclove Probiotics. Het bedrijf maakt mengsels van verschillende bacteriestammen, als basis voor probiotica, voor meer dan zeventig klanten wereldwijd. Naast de receptie staat een kast, met daarin een soort medicijndoosjes. Het zijn voorbeelden van probiotica-producten in pil- of poedervorm uit bijvoorbeeld Frankrijk, China, Rusland en Mexico.

Het uitstrijken van bacteriën gebeurt met een machine.
Elles Lalieu voor NEMO KennislinkBacteriën tellen
Bij de receptie ontmoet ik educatiemedewerker Gizem Yikilmaz. Zij neemt me mee naar het laboratorium. We komen in een kleine ruimte, die vrijwel direct wordt onderbroken door een blauwe lijn. Vanaf dat punt moeten we een labjas aan. Yikilmaz laat me een machine zien die automatisch bacteriën kan uitstrijken op een voedingsbodem. Dat proces heet uitplaten. Ze pakt een leeg petrischaaltje met medium, de voedingsbodem voor bacteriën, en klikt dat in het apparaat. “Nu staat de machine stil, maar normaal gesproken gaat de plaat met het petrischaaltje draaien”, legt ze uit. “De bacteriën komen dan in een soort cirkel- of spiraalvorm op de voedingsbodem. Die vorm zie je in onze petrischaatljes dus ook steeds terug.”
Na het uitplaten verdwijnen de bacteriën voor ongeveer 48 uur in een stoof van 37°C. Onder die omstandigheden kunnen de meeste bacteriën, die binnen het bedrijf gebruikt worden, zich goed vermenigvuldigen. Als de bacteriën gegroeid zijn, telt een medewerker hoeveel kolonies er in een petrischaaltje zitten. Dat gaat deels geautomatiseerd. Door een aantal kolonies ‘aan te tikken’, telt het apparaat en berekent het op basis van een raster hoeveel bacteriën er ongeveer aanwezig zullen zijn in het hele schaaltje.

Medewerkers tellen bacterieplaten om te controleren hoe goed de bacteriën zijn gegroeid. Dankzij het raster op de telmachine is het niet nodig om alle kolonies handmatig te tellen.
Elles Lalieu voor NEMO KennislinkDeze bacteriekweken zijn nodig om onderzoek te kunnen doen naar de werkzaamheid van een product. “Als je een product wilt hebben dat op de darmen werkt, moet een deel van de bacteriën daar wel terecht komen”, legt Yikilmaz uit. “Dat testen we door bacteriën te onderwerpen aan een maag-darmsimulatie.” Ze laat me een aantal petrischaaltjes met bacteriën zien. Het eerste schaaltje (product direct na inname) heeft op het oog meer bacteriën dan het laatste schaaltje (product in de dunne darm). Met berekeningen bepalen de onderzoekers of voldoende bacteriën de passage door het maag-darmkanaal overleven.
Soorten onderscheiden
Aan de andere kant van het laboratorium is een medewerker bezig met een kleurentest. Met een pipetje brengt hij een paarse bacterieoplossing in kleine welletjes op een teststrip. “In ieder welletje zit een suiker”, legt hij uit. “Sommige bacteriën zullen zo’n suiker om kunnen zetten, andere bacteriën niet. Als de suiker niet wordt omgezet, blijft de kleur paars. Als de suiker wel wordt omgezet, kleurt het welletje geel. In één test kijken we naar vijftig verschillende suikers. Zo krijg je een uniek kleurenprofiel, waaraan je kunt zien met welke bacteriesoort je te maken hebt.”

Deze kleurentest is net ingezet, dus zijn alle welletjes nog paars. Op het moment dat bacteriën suikers om gaan zetten, zullen sommige welletjes geel kleuren.
Elles Lalieu voor NEMO Kennislink“Dit is een van de tests die we gebruiken om te controleren of in onze formuleringen echt alleen de soorten zitten die we erin hebben gestopt”, vult Yikilmaz aan. De kleurentest onderscheidt tot op het niveau van de soort. Je kunt er bijvoorbeeld verschillende melkzuurbacteriën (Lactobacillus acidophilus en Lactobaccilus casei) mee opsporen. Maar dan ben je er nog niet. “Want”, zo zegt Yikilmaz, “de ene Lactobaccilus casei is de andere niet. Verschillende bacteriestammen kunnen hele verschillende eigenschappen hebben. Om onderscheid te kunnen maken tussen stammen kijken we sinds een jaar of vijf ook naar het DNA.”
Probiotica mengen
In de collectie van Winclove Probiotics zitten inmiddels ongeveer honderd stammen. De meeste daarvan worden gebruikt in producten en sommige zijn nog in de onderzoeksfase. Achterin het laboratorium staan vier fermentoren waar ongeveer twee liter vloeistof in past. Daarin kunnen bacteriën binnen één à twee dagen tot volledige groei komen. Er staat ook een kleine vriesdroger. Door vriesdrogen wordt al het water uit de bacteriën onttrokken en zijn ze langer houdbaar. Gevriesdroogde bacteriën zijn het basisbestanddeel van de probiotica.
“Met de fermentoren en de vriesdroger in het laboratorium kunnen we onderzoek doen naar de optimale kweekcondities van bacteriën”, legt Yikilmaz uit. “De bacteriën die we gebruiken in de producten worden extern, op grote schaal, gefermenteerd en komen dan gevriesdroogd bij ons binnen.” Ze neemt me mee naar de productieafdeling om te laten zien hoe het samenstellen van probiotica in zijn werk gaat. Mannen in blauwe overalls en compleet met haarnetje, mondkapje en handschoenen lopen achter gesloten deuren ijverig heen en weer. Eén van de mannen giet grote hoeveelheden poeder in een soort tank. Zijn wimpers zijn helemaal wit van het stof dat eraf komt.

Op de productieafdeling worden gevriesdroogde bacteriën gemengd met de juiste hoeveelheid hulpstoffen.
Elles Lalieu voor NEMO Kennislink“In de producten zitten naast gevriesdroogde bacteriën ook hulpstoffen, bijvoorbeeld om de maagoverleving van de bacteriën te bevorderen of ze langer houdbaar te maken”, vertelt Yikilmaz. Alle stoffen die in de tank gaan, moeten goed gemengd worden. Dat gebeurt in de mengruimte.” Op het moment dat ik er ben, is er net een tank klaar. Deze wordt van de menger afgekoppeld en naar de verpakkingsafdeling gereden. Er komt direct een nieuwe tank aan om te mengen. “We hebben maar één menger, dus dat is altijd strak gepland”, lacht Yikilmaz.
Klachten verminderen
We lopen de trap op naar de kantoren van het bedrijf. Daar spreek ik met Karen Koning, hoofd van de afdeling educatie. Zij legt me nog iets meer uit over het werken met bacteriën. “In onze producten zitten gemiddeld drie tot negen stammen”, zegt ze. “We werken voornamelijk met stammen die al op de markt zijn toegelaten voor consumptie. Dat zijn bijvoorbeeld natuurlijke darmbacteriën, maar ook bacteriën uit voeding, zoals yoghurt, brood of wijn. Dat bacteriën die veiligheidsstatus al hebben, is een groot voordeel. Dan duurt het geen tien tot vijftien jaar om een product te ontwikkelen, maar slechts één tot vier jaar. Dat is voor een consument die ergens op zit te wachten trouwens nog steeds lang.”

Voorbeeld van gevriesdroogde bacteriën. De korreltjes zien eruit als waspoeder, maar hebben geen geur.
Elles Lalieu voor NEMO KennislinkBacteriën beïnvloeden elkaar, zowel positief als negatief. Je kunt dus niet zomaar zes bacteriestammen bij elkaar gooien en hopen dat het goed komt. Het is zaak om bacteriën te selecteren die nuttige eigenschappen hebben voor de gebruiker. “Wij stellen onze formuleringen samen op basis van wetenschappelijke kennis en doen ook klinische studies”, legt Koning uit. “Het nadeel van een klinische studie is wel dat de gebruikers vaak een homogene groep zijn, bijvoorbeeld alleen vrouwen. Daarom doen we, als het product eenmaal op de markt is, ook gebruikersproeven. We bieden het product aan via gezondheidsprofessionals en vragen achteraf na of patiënten er volgens hen baat bij hebben gehad.”
Nieuw veld aftasten
Want dat is het uiteindelijke doel: dat patiënten er iets aan hebben. “Chronische darmziekten zoals de ziekte van Crohn of colitis ulcerosa kunnen we met probiotica niet genezen. Dat zou geen realistisch doel zijn”, stelt Koning. “Maar we kunnen wel de klachten verminderen. Sommige patiënten met colitis ulcerosa hebben gemiddeld acht keer per dag diarree en komen daardoor soms de deur niet meer uit. Als je dat terug kunt brengen naar drie keer per dag is dat een kleine vooruitgang, maar patiënten zijn daar al superblij mee.”
Ook voor hooikoorts en chronische urineweginfecties worden er inmiddels producten getest die de klachten lijken te verminderen. Daarnaast doet Winclove Probiotics onderzoek op een heel nieuw gebied; hersenziekten. Koning: “Er zijn steeds meer aanwijzingen dat hersenziekten, zoals Parkinson, vanuit de darm ontstaan. Dit is echt een nieuw veld dat we nog aan het aftasten zijn.” Om de kennis verder te vergroten, is het bedrijf partner in verschillende wetenschappelijke congressen. “We bemoeien ons niet met de inhoud. Dat doet een onafhankelijke wetenschappelijke commissie. Maar we willen wel graag onderzoekers samenbrengen, want alleen dan kom je verder.”